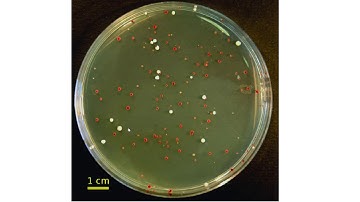
Genetics - UV Lethality and Mutation in Yeast part 1

⬇ DOWNLOAD NOW
Kalau muncul iklan pop-up, tutup lalu klik tombol kembali
Download lagu petite mutants in yeast ( detailed notes ) | B.Sc. and M.Sc. | petite mutation in yeast secara gratis hanya untuk keperluan promosi. Dukung artis favorit kamu dengan membeli musik original di iTunes atau platform resmi lainnya.
 Petite mutants in Baker's yeast Saccharomyces cerevisiae | CSIR NET Life Sciences | Bilingual
Petite mutants in Baker's yeast Saccharomyces cerevisiae | CSIR NET Life Sciences | Bilingual
 Cytoplasmic Inheritance or Mitochondrial Inheritance- Petite Mutants in Yeast
Cytoplasmic Inheritance or Mitochondrial Inheritance- Petite Mutants in Yeast
 Cytoplasmic inheritance , Petite mutants in Yeast
Cytoplasmic inheritance , Petite mutants in Yeast
 Mitochondrial Inheritance
Mitochondrial Inheritance
 Genetically Modifying Yeast Speed Run
Genetically Modifying Yeast Speed Run
Genetics - UV Lethality and Mutation in Yeast part 1
Genetics - UV Lethality and Mutation in Yeast part 1
 Extranuclear Inheritance by Mitochondria. (Inheritance pattern of Petite Mutant). Genetics.
Extranuclear Inheritance by Mitochondria. (Inheritance pattern of Petite Mutant). Genetics.
 Mitochondrial inheritance in yeast |Genetics| 3rd sem botany| Dr. Rajib Borah| Assamese| Axomia Bio
Mitochondrial inheritance in yeast |Genetics| 3rd sem botany| Dr. Rajib Borah| Assamese| Axomia Bio